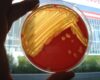

Liver disease in horses: diagnosis, liver enzymes and detection of toxins, infections, parasites
Haemonchus contortus: Diagnosis, treatment and prevention in sheep, goats and New World camels
In breeding mares, infections of the genital tract can primarily lead to infertility, abortions, and the birth of weak foals with septicaemia.
2024
In recent years, the number of domesticated alpacas and llamas as well as the absolute number of these animals has been steadily increasing.
The aim of hygiene measures in veterinary practices and clinics is to prevent the spread and transmission of infectious agents.
Throughout the season (spring - autumn), the ovaries in horse mares show physiologically cycle-related changes (development of follicles, ovulation, formation of Corpora lutea).
While horses are not large dogs, there are many procedures, such as dermatological examinations, that are very similar to those used in dogs.
The author addressed the topic of chronic weight loss in adult horses and discussed the subject of inflammatory bowl disease (IBD) in particular.
2023
A wide range of different detection methods are available to veterinarians for the diagnosis of infectious diseases.
WNV was first isolated in December 1937, from a 37-year-old, febrile woman in the West Nile district in the Northern Province of Uganda. In Europe, human cases were documented in the 1960's.
Apart from orthopaedic problems, intestinal diseases are the most frequent causes for consultations in the veterinary practice.
The expert discussed some recent studies that address the detection of silent carrier horses.
2022
Clinical signs of gastrointestinal complaints in horses are manifold. They include colic, diarrhoea, constipation or flatulence.
Hepatic diseases are quite common in equids. In addition to poisonous plants, toxins, parasitoses and neoplasms, they can also be caused by bacterial or viral infectious agents.
Strangles is caused by the gram-positive, β-haemolytic bacterium Streptococcus equi subspecies equi.
The work-up of equine respiratory diseases is based on anamnesis, clinical examination, endoscopic findings and pulmonary function tests...
2021
Platelets, also called thrombocytes, are an important component of blood coagulation.
The nomenclature of equine respiratory diseases has recently been revised.
Summer eczema is the most common itchy skin disease in horses.
As veterinarians, we are aware of the importance of emerging viral diseases. Especially, when spread rapidly and therapeutic options are limited.
2020
The horse’s digestive system is designed for the best possible utilisation of plant food. Digestion already begins with grinding the feed in the mouth and mixing it with saliva.
In veterinary medicine, too, non-invasive diagnostic and therapeutic approaches have become increasingly important in recent years
Before or at the beginning of the breeding season, special attention is paid to mares that were not in foal or aborted in the past year.
During the breeding season, the breeding suitability of all mares intended for breeding must be assessed.